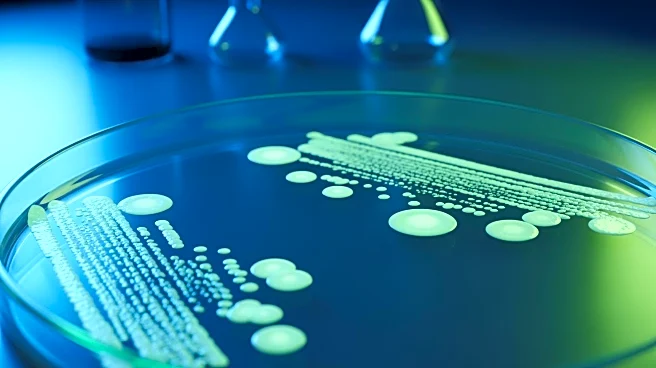
Experts Warn of Antimicrobial Resistance Becoming a Greater Threat Than Cancer by 2050

MELBOURNE, Australia (AP) — A surfer had minor injuries from being bitten by a shark Tuesday in the fourth attack off the coast of Australia's most populous state in three days.
The shark attacked the man's surfboard at Point Plomer, 460 kilometers (290 miles) north of the New South Wales state capital, around 9 a.m., officials said.
The man was lucky to survive with minor cuts, Kempsey-Crescent Head Surf Life Saving Club captain Matt Worrall said.
“The board seemed to take most of the impact,” Worrall told Australian Broadcasting Corp. “He made his own way into shore where he was assisted by locals.”
The bystanders drove the 39-year-old man to a hospital and he was later discharged.
In the earlier attacks, a man and a boy suffered critical leg wounds and the surfboard of another boy was bitten by sharks at Sydney locations Sunday and Monday.
Beaches along the New South Wales' northern coast and northern Sydney were closed indefinitely following the attacks, and electronic drumlines that alert authorities when a large shark has taken bait were deployed off the Sydney coast.
Authorities warned that recent rainfall has left the water off area beaches murky, which increased the risk of bull shark attacks. Bull sharks are responsible for most attacks around Sydney.
“If anyone's thinking of heading into the surf this morning anywhere along the northern beaches, think again. We have such poor water quality that’s really conducive to some bull shark activity,” Surf Life Saving NSW chief executive Steve Pearce said.
“If you're thinking about going for a swim, just go to a local pool because at this stage, we’re advising that beaches are unsafe,” Peace added.
On Sunday, a 12-year-old boy was attacked after jumping from a 6-meter (20-foot) ledge known as Jump Rock near Shark Beach inside Sydney Harbor. Police have credited the boy’s friends with saving his life by jumping from the cliff during the attack and dragging him back to shore.
“Those actions of those young men are brave under the circumstances and very confronting injuries for those boys to see,” Supt. Joseph McNulty said.
News media have reported that the boy lost both legs in the attack.
Around noon Monday, an 11-year-old boy was on a surfboard that was attacked by a shark at Dee Why Beach, an ocean beach north of Manly. The shark bit off a chunk of the board, but the boy escaped uninjured.
A surfer in his 20s was bitten on a leg by a shark off North Steyne Beach on the Pacific Ocean coast in the northern suburb of Manly at 6:20 p.m. Monday, police said. Bystanders pulled him from the water before an ambulance took him to a hospital in a critical condition.
All three Sydney beaches have some form of shark protection netting. It was not immediately clear where the attacks occurred in relation to that netting.
Pearce said the scene of the latest attack was isolated and did not have shark netting.
Dee Why Beach is close to the beach where a 57-year-old surfer was killed by a suspected white shark last September.
In November, a 25-year-old Swiss tourist was killed and her partner was seriously injured trying to save her as they swam off a national park north of Sydney.